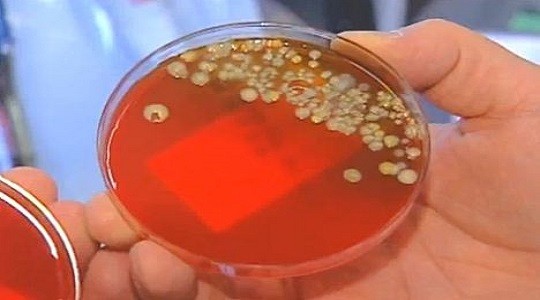

Πόσα μικρόβια “κολλήσατε” το κινητό σας;
Τα κινητά έχουν πολλά μικρόβια και αυτό είναι γνωστό και από παλαιότερες μελέτες. Aυτό που δεν γνωρίζαμε, όμως, είναι ότι το κάθε κινητό “μοιάζει” μικροβιακά στον ιδιοκτήτη του. Συγκεκριμένα, όπως υποστηρίζουν Αμερικανοί επιστήμονες, τα smartphones αντικατοπτρίζουν τον προσωπικό κόσμο μικροβίων των ιδιοκτητών τους.
Πάνω από το 80% των κοινών βακτηριδίων που συνθέτουν το προσωπικό βακτηριακό μας “δακτυλικό αποτύπωμα” καταλήγουν στις οθόνες των κινητών, σύμφωνα με μία νέα μελέτη.
Τα διάφορα προσωπικά αντικείμενα, όπως τα κινητά τηλέφωνα, μπορεί να είναι χρήσιμα για την παρακολούθηση της εξάπλωσης των βακτηρίων. Αντανακλούν το προσωπικό μας μικροβίωμα, δηλαδή τα τρισεκατομμύρια των διαφόρων μικροοργανισμών που ζουν μέσα και πάνω στο σώμα μας, λένε οι ειδικοί.
Έχει βρεθεί ότι οι χρήστες κινητών τηλεφώνων αγγίζουν τις συσκευές τους κατά μέσο όρο 150 φορές την ημέρα. ”Έχουμε περισσότερα κοινά από ό, τι μια απλή συναισθηματική σύνδεση με το κινητό μας τηλέφωνο και ένα από αυτά είναι ότι φέρουν πάνω τους το προσωπικό μας μικροβίωμα”, λέει ο Δρ James Meadow από το Πανεπιστήμιο του Όρεγκον.
Οι επιστήμονες έχουν διαπιστώσει ότι υπάρχει μια αλληλοεπικάλυψη μεταξύ των μικροοργανισμών που υπάρχουν στο σώμα μας και εκείνων που εντοπίζονται στις οθόνες των smartphones. Υποστηρίζουν ότι αυτό το εύρημα θα μπορούσε μια μέρα να χρησιμοποιηθεί για την παρακολούθηση της έκθεσης των ανθρώπων στα βακτήρια.
Οι ερευνητές εξέτασαν το DNA των μικροβίων που βρίσκονται στο δείκτη της παλάμης, καθώς και το DNA των μικροβίων που βρίσκονται στην οθόνη του κινητού μιας ομάδας 17 εθελοντών.
Συνολικά εντοπίστηκαν 7.000 διαφορετικά βακτήρια σε 51 δείγματα. Κατά μέσο όρο, το 22% των βακτηρίων ήταν κοινά μεταξύ δείκτη και κινητού. Το 82% περίπου από τα πιο κοινά βακτήρια που υπήρχαν στα δάχτυλα των συμμετεχόντων βρέθηκαν επίσης και στα τηλέφωνά τους.
Στα μικρόβια που βρέθηκαν περιλαμβάνονται τρεις οικογένειες μικροβίων που εντοπίζονται συνήθως στο δέρμα ή στο στόμα μας, όπως ο στρεπτόκοκκος, ο σταφυλόκοκκος, και το κορυνοβακτηριδιο. Οι ερευνητές κατέληξαν στο συμπέρασμα ότι τα αντικείμενα που χρησιμοποιούμε περισσότερο είναι και αυτά που μας «μοιάζουν» περισσότερο από πλευράς μικροβιακού φορτίου. Η μελέτη δημοσιεύεται στην επιθεώρηση PeerJ.
Στο πλαίσιο τώρα μιας παλαιότερης μελέτης από το Πανεπιστήμιο της Αριζόνας, οι ειδικοί εντόπισαν στα κινητά και άλλα βακτήρια όπως ο ανθεκτικός στη Μεθικιλλίνη, ένα βακτήριο ανθεκτικό στα περισσότερα αντιβιοτικά που είναι δυνητικά θανατηφόρο αν εισέλθει στο κυκλοφορικό σύστημα. Οι ερευνητές από το Πανεπιστήμιο της Αριζόνας εξέτασαν 25 κινητά τηλέφωνα, και διαπίστωσαν ότι το 20% φιλοξενούσε το συγκεκριμένο βακτήριο. Ως μέτρο πρόληψης οι ειδικοί προτείνουν να απολυμαίνουμε το κινητό μας με αντιμικροβιακά πανάκια που δεν προκαλούν ζημιά στο τηλέφωνο όπως π.χ. το οινόπνευμα που μπορεί να εισχωρήσει στο εσωτερικό του τηλεφώνου.
Πηγή: pathfinder.gr
Διαβάστε επίσης